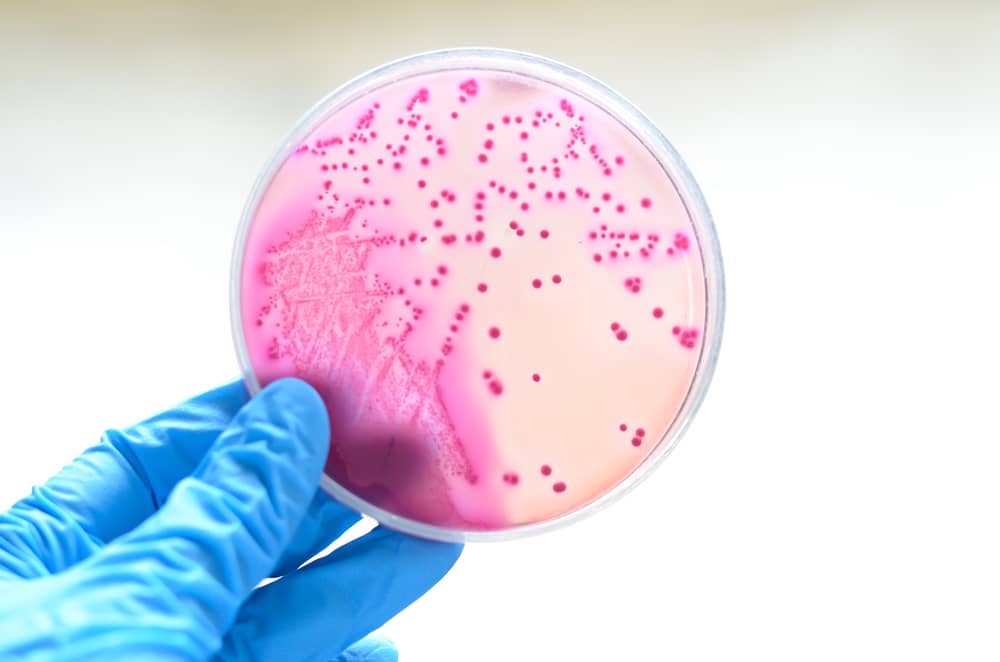
tại sao gram âm bắt màu hồng hoặc đỏ
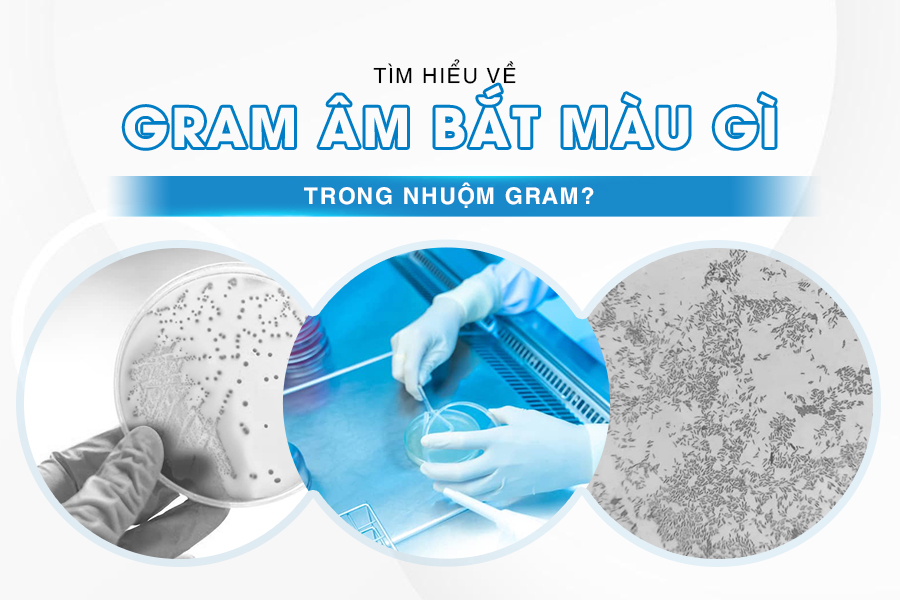

Gram Âm Bắt Màu Gì Trong Nhuộm Gram?
Gram Âm Bắt Màu Gì?
Trong nhuộm Gram, vi khuẩn được chia thành hai nhóm: Gram dương và Gram âm. Vậy Gram âm bắt màu gì? Vâng đó chính là Gram âm sẽ bắt màu hồng hoặc đỏ sau khi nhuộm Gram, do vi khuẩn Gram âm hấp thụ safranin sau khi phức hợp nhuộm tím ban đầu bị rửa trôi. Màu này đặc trưng cho các loài như Escherichia coli, Pseudomonas aeruginosa, hoặc Salmonella Typhi, với biến thiên từ hồng nhạt đến đỏ đậm tùy độ tuổi mẫu và chất lượng nhuộm. Màu hồng hoặc đỏ là dấu hiệu nhận biết nhiễm trùng bởi nhóm vi khuẩn Gram âm, thường kháng thuốc hơn và liên quan đến các bệnh nghiêm trọng như nhiễm trùng nghiêm trọng.

Lý Do Tại Sao Gram Âm Bắt Màu Hồng Hoặc Đỏ?
Màu hồng hoặc đỏ của Gram âm xuất phát từ cấu trúc thành tế bào đặc biệt và các phản ứng hóa học trong quy trình nhuộm. Cụ thể như bạn hãy xem qua phân tích của Lintech JSC dựa trên cơ chế được xác nhận qua các tài liệu nghiên cứu.
Sự Khác Biệt Về Cấu Trúc Thành Tế Bào Gram Âm
- Peptidoglycan Mỏng: Thành tế bào Gram âm chỉ chứa 10% dày 2 đến 7 nm, so với 90% 20 đến 80 nm ở Gram dương. Lớp này nằm giữa màng trong và màng ngoài giàu lipopolysaccharide, không đủ dày để giữ phức hợp nhuộm sơ cấp.
- Hàm Lượng Lipid Cao: Màng ngoài chứa 20 đến 30% lipid, dễ bị hòa tan bởi dung môi hữu cơ như ethanol hoặc acetone. Điều này làm tế bào “rò rỉ” trong bước tẩy màu, khiến phức hợp nhuộm sơ cấp thoát ra. Porins và LPS trong màng ngoài tạo hàng rào bảo vệ nhưng không ngăn được mất màu tím.
Kết quả: Cấu trúc mỏng và lipid cao khiến Gram âm không giữ được màu tím, dẫn đến nhuộm chuyển sang màu hồng hay đỏ.
Cơ Chế Hóa Học Chi Tiết Trong Quy Trình Nhuộm
- Nhuộm Sơ Cấp và Cố Định: Crystal violet CV+, một dye dương điện, thấm qua thành tế bào, kết hợp với các thành phần âm điện trong tế bào, nhuộm tất cả vi khuẩn tím. Iodine I- tương tác với CV+ để tạo phức hợp CV-I lớn, tạm thời bị kẹt trong tế bào Gram âm.
- Tẩy Màu Quyết Định: Ethanol hoặc acetone hòa tan lipid ở màng ngoài, làm lớp peptidoglycan mỏng co lại, tạo lỗ rò rỉ để CVI lớn bị rửa trôi hoàn toàn. Tế bào Gram âm trở nên trong suốt, trong khi Gram dương giữ CVI nhờ lưới peptidoglycan dày và ít lipid.
- Nhuộm Phản: Safranin, một dye dương điện khác, thấm vào tế bào đã mất CVI, kết hợp với các thành phần âm điện còn lại, tạo màu hồng đỏ ổn định. Lipid cao không cản trở safranin, đảm bảo màu sắc rõ nét.
- Yếu Tố Ảnh Hưởng Màu Sắc:
- Độ Tuổi của mẫu: mẫu già trên 24 giờ có peptidoglycan yếu, dễ rò rỉ hơn, dẫn đến màu hồng nhạt hoặc không đồng đều.
- Nồng Độ Decolorizer: Quá mạnh có thể làm Gram dương cũng mất màu tím, dẫn đến nhầm lẫn.Loại Safranin: Safranin O cho màu đỏ đậm hơn so với các biến thể khác, là chuẩn trong nhuộm Gram.
- Gram Variable: Một số Gram âm như Acinetobacter có màng ngoài kháng tẩy màu một phần, gây kết quả hỗn hợp hồng hay tím, dễ dẫn đến chẩn đoán sai nếu không kiểm tra kỹ.

Màu hồng đỏ không chỉ là kết quả nhuộm mà còn phản ánh sự thích nghi tiến hóa của Gram âm: màng ngoài giàu lipid giúp kháng thuốc nhưng dễ mất CVI, tạo điều kiện cho safranin thấm vào. Đây là dấu hiệu chẩn đoán quan trọng, đặc biệt với các bệnh như nhiễm trùng đường tiết niệu E. coli hay thường như thương hàn.
Bảng Phân Tích Lý Do Gram Âm Bắt Màu Hồng hay Đỏ
Dưới đây là bảng tóm tắt lý do Gram âm bắt màu hồng hay đỏ
| Yếu Tố | Mô Tả Chi Tiết | Ảnh Hưởng Đến Màu Hồng hoặcĐỏ |
|---|---|---|
| Peptidoglycan Mỏng | Chỉ 2 đến7 nm, không giữ được phức hợp CVI sau tẩy màu. | Rửa trôi mất màu tím, bắt safranin. |
| Hàm Lượng Lipid Cao | Màng ngoài tan tan trong ethanol, làm rò rỉ phức hợp nhuộm. | Tế bào trong suốt, dễ bắt safranin đỏ. |
| Cơ Chế CV-I | Phức hợp lớn bị loại bỏ do lớp màng yếu. | Không giữ tím, chuyển sang hồng. |
| Safranin Phản | Dye dương điện thấm vào tế bào đã mất CVI. | Tạo màu hồng hoặcđỏ ổn định. |
| Yếu Tố Biến Thiên | Mẫu cũ hoặc smear dày làm peptidoglycan yếu hơn. | Màu hồng nhạt hoặc gram variable. |
Ý Nghĩa Của Màu Hồng Đỏ Trong Gram Âm
Gram âm bắt màu hồng đỏ là dấu hiệu quan trọng trong lĩnh vực vi sinh, giúp phân biệt đâu là Gram Âm và đâu là Gram Dương đồng thời phản ánh cấu trúc thành tế bào mỏng và giàu lipid. Màu này không chỉ giúp phân loại vi khuẩn mà còn định hướng điều trị kháng sinh, đặc biệt với các nhiễm trùng kháng thuốc như E. coli hoặc Pseudomonas aeruginosa. Hiểu rõ cơ chế hóa học và yếu tố biến thiên mẫu cũ, Gram-variable giúp kỹ thuật viên tránh chẩn đoán sai, nâng cao chất lượng phân tích phòng xét nghiệm.

Câu Hỏi Thường Gặp FQA Về Gram Âm Bắt Màu
-
Vi khuẩn Gram âm bắt màu gì trong nhuộm Gram?
- Màu hồng hoặc đỏ dưới kính hiển vi dầu (1000x), do hấp thụ safranin sau khi mất màu tím.
-
Tại sao vi khuẩn Gram âm không giữ được màu tím?
- Vì lớp peptidoglycan mỏng và màng ngoài nhiều lipid bị hòa tan trong quá trình tẩy màu.
- Tại sao màu hồng đỏ của Gram âm có thể nhạt hoặc không rõ?
- Do mẫu cũ, nhuộm sai kỹ thuật, hoặc safranin kém chất lượng.
- Gram variable ở vi khuẩn Gram âm là gì?
- Là hiện tượng nhuộm không đồng nhất (vừa tím vừa hồng), thường gặp ở Acinetobacter hoặc mẫu quá dày.
Nguồn: ASM Gram Stain Protocol, NCBI StatPearls, Wikipedia, cập nhật 2025.

English